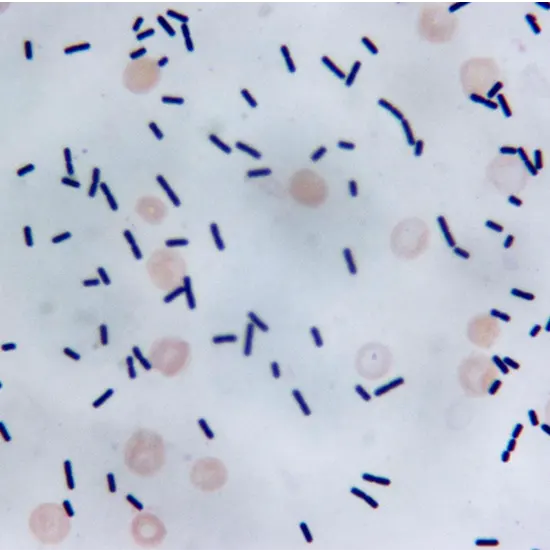

Book Clostridium Difficile In Stool By PCR Appointment Online Near me at the best price in Delhi/NCR from Ganesh Diagnostic. NABL & NABH Accredited Diagnostic centre and Pathology lab in Delhi offering a wide range of Radiology & Pathology tests. Get Free Ambulance & Free Home Sample collection. 24X7 Hour Open. Call Now at 011-47-444-444 to Book your Clostridium Difficile In Stool By PCR at 50% Discount.
Clostridium difficile is a bacterium that can cause diarrhea and inflammation of the colon, known as colitis. The most common method for detecting C. difficile in stool samples is through polymerase chain reaction (PCR) testing. PCR testing is a molecular technique that amplifies and detects the DNA of the bacterium in the stool sample. It is a highly sensitive and specific test that can detect even small amounts of the bacterium in the stool sample.
PCR testing for C. difficile is often used in cases where other tests, such as toxin assays or culture, have not provided a clear diagnosis or when rapid results are needed. It can also be used to monitor patients who are being treated for C. difficile infection to confirm that the bacterium has been eradicated.
It is important to note that Clostridium difficile in Stool by PCR alone cannot confirm the diagnosis of C. difficile infection.
>>Stool sample
You need to provide the clinical information, such as symptoms and medical history to the doctor
The presence of C. difficile in the stool does not necessarily mean that the bacterium is causing the symptoms, as it can also be present as a normal part of the gut microbiota in some individuals.
The average price for this test is seen to differ from one center to another. The price range is said to be between INR 2500 to INR 8500 in Delhi, India.
| Test Type | Clostridium Difficile In Stool By PCR |
| Includes | Clostridium difficile in Stool by PCR (Gastroenterology) |
| Preparation | |
| Reporting | Within 24 hours* |
| Test Price |
₹ 3250
|

When there is PCR testing, it is considered to be a sensitive method for detection of the ten major enteric pathogens. When the faecal PCR test which detects the parasite and the bacterial DNA, which makes it more accurate technique than the standard Micro, Culture and Sensitivity (MC&S) which normally gets requested by the conventional laboratories?
Among 117 cases, It is seen that sensitivities of the real-time PCR, C. difficile toxin assay and the culture for your C. difficile is assessed to be around 87.2% (102 cases; 95% CI, with 80.7%–92.8%), 48.7% (57 cases; 95% CI, 41.0%–59.8%), and the percentage of 65.0% (76 cases; 95% CI, 60.2%–78.5%), respectively. Along with this, the sensitivity of real-time PCR has been considered higher for C. difficile.
If PCR test comes out to be positive, we could also determine with an absolute certainty that patient presents with toxigenic C difficile, while final interpretation also comes out to be positive. It is also important to further recall that PCR would not distinguish between the active disease and the asymptomatic carriage.
At the minimum level, when the isolation gets recommended for a period of 48 hours after the symptom resolution. It is also seen that however, in the high-incidence settings with correct isolation that gets extended up until the discharge stage. While, you could encounter a latter recommendation for the prolonged isolation which gets based upon the evidence that C. difficile sheds continuosuly for about least 1 to 4 weeks after the treatment process.
The C. diff stool culture is considered to be a specific kind of culture with the different which typically requested the bacterial stool culture. When culture gets grown in the anaerobic environment, by making it even more labor intensive and a relatively slower turn-around time.
This is the test which looks at the bowel movement (stool) for any harmful substances called the toxins which gets produced by the Clostridioides (formerly Clostridium) and difficile bacteria. It is seen that the gastrointestinal (GI) tract becomes home to many of the healthy bacteria, which sometimes C. difficile becomes one of them.
Yes, everybody is eligible for a FREE Home for Clostridium Difficile in Stool by PCR from Ganesh Diagnostic and Imaging Center. Our phlebotomist would collect your stool sample from the convenience of your home. We also provide online support and would send your reports digitally on your phone through whatsapp as well.
Yes, a free doctor’s consultation is available for all individuals. Either before the test, or after the test, you can avail this facility at our center, online or in person.
Early check ups are always better than delayed ones. Safety, precaution & care is depicted from the several health checkups. Here, we present simple & comprehensive health packages for any kind of testing to ensure the early prescribed treatment to safeguard your health.